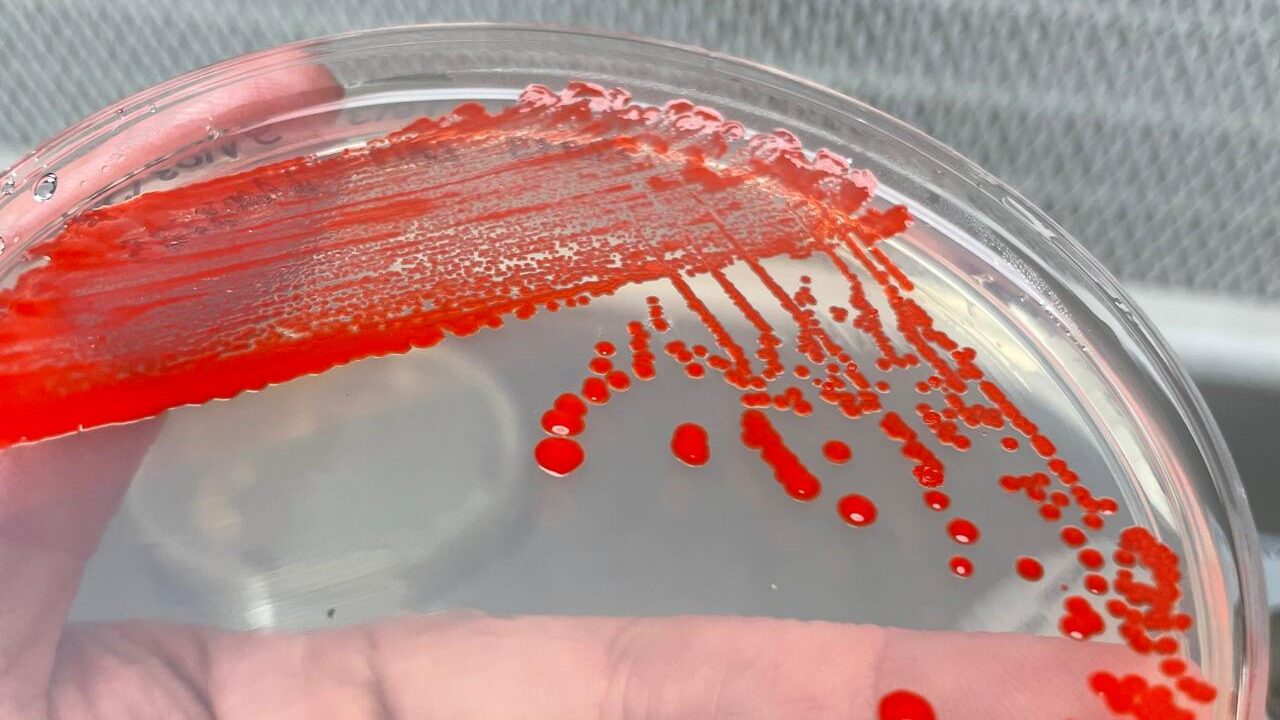

El pasado lunes 30 de marzo se presentaron los avances de los Proyectos de Innovación Pública con Impacto Territorial ante el Comité Ejecutivo de la Red de Innovación del Consorcio de Universidades del Estado de Chile (CUECH), instancia que permitió conocer el avance de las iniciativas desarrolladas asociativamente por las universidades estatales.
En este contexto, Isabel Araos, coordinadora de la Red de Innovación CUECH, destacó la relevancia del pilotaje y del trabajo articulado entre las 18 universidades estatales: “Este trabajo permite relevar el valor territorial y público de las iniciativas, fortaleciendo la colaboración interuniversitaria y la generación de soluciones concretas desde los territorios para los desafíos del país”.
Estas iniciativas forman parte del trabajo de la Red orientado a fortalecer la innovación pública, la investigación aplicada y la generación de conocimiento con pertinencia territorial, abordando desafíos concretos a través de la colaboración entre universidades del Estado.

En la zona norte, las universidades de Tarapacá, Arturo Prat, Antofagasta y Atacama desarrollan el proyecto MIREN, enfocado en la valorización de minerales, relaves y nanomateriales, con el objetivo de diversificar la matriz productiva regional mediante el uso de tecnologías como la síntesis de nanomateriales a partir de energía solar. El equipo está integrado por el Dr. Mauricio Morel (UDA) coordinador responsable de la iniciativa, junto a la Dra. Sapana Jaudoun (UTA), Mangalaraja Ramalinga Viswanathan (UNAP) y Felipe Galleguillos (UNAP).
En la zona centro, las universidades de La Serena, Valparaíso y Playa Ancha avanzan en el desarrollo de una plataforma de datos orientada a mejorar la atención de personas neurodivergentes, promoviendo la inclusión a partir de evidencia y herramientas digitales. Equipo integrado por Jacqueline Concha (UV), coordinadora responsable del proyecto, César Galindo (UV), Tomás Reyes (UPLA) y Sebastián Corral (ULS).

Por su parte, en la zona centro-sur, las universidades de O’Higgins, Talca y del Biobío trabajan en la creación de una cohorte de personas mayores para estudiar el envejecimiento saludable y condiciones como la sarcopenia, contribuyendo al diseño de políticas públicas en salud. La iniciativa es liderada por Sebastián Jannas (UOH) junto a Jéssica Espinoza (UTALCA) y Carmen Luz Muñoz (UBB).
En la zona sur y austral, las universidades de La Frontera, Los Lagos, Aysén y Magallanes desarrollan un consorcio bacteriano con potencial biotecnológico aplicado a la industria acuícola, específicamente en la dieta de salmones. El proyecto es coordinado por Alex González (ULAGOS) e integrado por el Dr. Michel Abanto (UFRO), Jorge Toledo (UAYSEN) y Nancy Calisto (UMAG).
En tanto, en la Región Metropolitana, las universidades de Chile, Santiago de Chile, Metropolitana de Ciencias de la Educación y Tecnológica Metropolitana lideran un diagnóstico integral del ecosistema de innovación, con el objetivo de generar bases para un observatorio territorial y fortalecer el liderazgo de las universidades estatales en esta materia. Este proyecto es coordinado por Héctor Torres (UTEM) y participan como integrantes del equipo, Leonidas Ibarra (USACH), Katia Soto (UCH) y Joel Álvares (UMCE).
Conoce en detalle los proyectos
Durante la jornada, se abordaron desafíos comunes en la implementación de los proyectos, destacando el proceso de una articulación asociativa e incidencia pública en línea con los principios y ejes estratégicos que promueve la Red de Innovación CUECH. Estas iniciativas se enmarcan en el proyecto “Innovación Pública de las Universidades Estatales para el Desarrollo Sostenible” (RED 23994), que busca fortalecer el rol de las universidades del Estado como actores clave en la generación de innovación con sentido público y pertinencia territorial, financiado por la Subsecretaría de Educación Superior a través del Plan de Fortalecimiento de las Universidades Estatales (2023).
Puedes revisar cada uno de los proyectos en detalle, haciendo click aquí.



